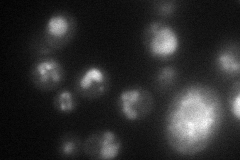
YML132W
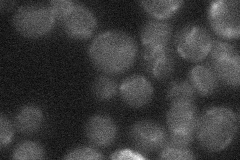
YML132W
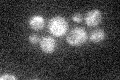
YML132W

View description
Protein involved in salt resistance; interacts with sodium:hydrogen antiporter Nha1p; member of the DUP380 subfamily of conserved, often subtelomerically-encoded proteins
Localization:
Intensity:
Fold change:
Significance:
-
C’ GFP library in SD

below threshold14.23 -
N' NOP1pr-GFP in SD
vacuole43.3789 -
N' TEF2pr-mCherry in SD

vacuole93.6235 -
N' NATIVEpr-GFP in SD
below threshold16.6358 -
N' TEF2pr-VC and Cyto-VN in SD

below threshold25.6084 -
C’ GFP library in SD+DTT

cytosol15.221.06No -
C’ GFP library in SD+H2O2
cytosol14.511.01No -
C’ GFP library in Starvation Media

cytosol17.961.26No -
C’ GFP library on the background of Pup2-DaMP

below threshold -
C’ GFP library on the background of CCT mutant

below threshold15.07771.05906No
